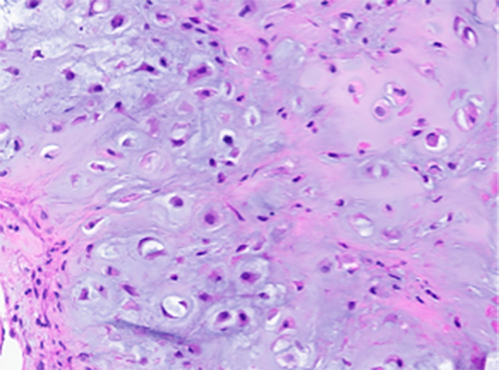

April 2024 Case
Case Presentation
A male patient in his 70s presented initially at an outside endocrinology clinic for evaluation of a right neck mass which had been progressively growing the last 9 months, with associated dysphagia and hoarseness. Clinic ultrasound of the thyroid revealed a left 1.2cm, left 0.6 cm (too small to biopsy), and right 3.4 cm thyroid nodules. Lab studies were within reference range (TSH 1.67, T4 1.0). Lymph node mapping showed a suspicious lymph node immediately adjacent to the mass (medial to the carotid). An initial fine needle aspiration with subsequent core biopsy of the thyroid mass was performed.
Cytology Microscopic Findings and Ancillary Studies
Examination of the cytologic smears revealed a hypercellular specimen composed of multiple clusters of atypical epithelioid cells with eccentric nuclei and cytoplasmic vacuoles, in a background of abundant extracellular chondro-myxoid matrix material (greenish blue appearance on Papanicolaou-stain slides).

Papanicolaou stain (100X)

Papanicolaou stain (400X)
The clinical history, radiologic findings along with the cytomorphologic features are highly suspicious for a malignant process. Our differential diagnoses primarily includes a chondrosarcoma arising from thyroid cartilage and to a lesser degree an anaplastic thyroid carcinoma with chondrosarcomatous differentiation. A more remote possibility would include a chordoma.
Immunohistochemical studies were performed on direct smears and were negative for keratins (AE1/AE3) and TTF-1 (Thyroid Transcription Factor-1). S100 (not verified) was positive in tumor cells.
In light of the morphologic and immunohistochemical findings, a diagnosis of chondrosarcoma was favored. A subsequent CT Neck and core biopsy were performed for definitive tissue diagnosis.
Imaging and Histology Microscopic Findings
Imaging (CT Neck with contrast) demonstrated a 3.4 x 3.2 x 3.5 cm hypoattenuating mass lesion centered on the right thyroid cartilage with associated destructive changes of the thyroid cartilage and scattered calcified the lateral margin of the mass extends into the strap muscles which are displaced anteriorly and laterally with probable invasion or extension of the mass lesion into the strap muscle body and with medial extension into the right para-glottic space and right aryepiglottic fold.
Histological analysis of the biopsy demonstrated a cartilaginous lesion with increase cellularity, diffuse growth and moderate atypia. No high grade features was appreciated, including pleomorphic appearance and easily identifiable mitotic figures.

H&E stain (100X)
H&E stain (400X)
Diagnosis
Chondrosarcoma, Grade 2
Discussion
Chondrosarcomas of the larynx are rare locally aggressive malignancies characterized by the formation of cartilaginous matric and accounting for <1% of laryngeal neoplasms. When found in the larynx, they are usually a slow-growing tumor, most commonly originating from the cricoid cartilage (70%) with less than 20% in the thyroid cartilage.
In the diagnosis of chondrosarcoma, although the histological criteria are not fully defined, features such as cell and nuclear size irregularities, hypercellularity, hyperchromasia, nuclear pleomorphism and invasion into cartilage tissue contributes to the diagnosis of chondrosarcoma instead of chondroma. Therefore, making the diagnosis of a chondroid lesion by fine needle aspiration (FNA) is very challenging, particularly lower grade lesions. Cytologic features of low-grade chondrosarcoma could also overlap with enchondroma and metastatic carcinoma, most commonly renal cell carcinoma.
Laryngeal chondrosarcoma is graded histologically as grade 1, grade 2, and grade 3. Grade 1 chondrosarcomas contain binuclear and multinuclear chondrocytes but do not show mitosis. Grade 2 show increased cellularity and rare mitosis. Grade 3 are characterized by chondrocytes with a multinuclear appearance and increased mitotic activity. The rate of metastasis increases with grade and is 10% in grade 2 chondrosarcoma. Most laryngeal chondrosarcoma cases have a lower grade compared to other organ and have better prognosis than non-larynx localized chondrosarcoma and can be detected at an earlier stage.
The management of chondrosarcoma arising from the thyroid cartilage remains a challenge due to its rarity and the potential for local invasion. Managment may differ depending on the grade. In low-grade tumors, it is recommended to preserve laryngeal functions with treatments such as CO2 laser ablation and hemilaryngectomy, with long term follow-up in monitoring for recurrence or metastasis.
In conclusion, the case of chondrosarcoma arising from the thyroid cartilage presented here highlights the importance of meticulous evaluation and consideration of rare neoplasms in the head and neck region. The clinical, microscopic, and ancillary findings supported the diagnosis of chondrosarcoma, which was further confirmed by discussions with the multidisciplinary team.
Further research and collaboration among medical disciplines are essential to improve our understanding and management of rare tumors such as chondrosarcoma arising from the thyroid cartilage. This case reinforces the need for careful consideration and comprehensive workup of unusual presentations in the head and neck region to ensure timely and appropriate management for optimal patient outcomes.
References
- Awny, S., Zuhdy, M., Hamdy, O., Saleh, G A., Hassan, A H., Abdelkhalek, M., Mosaad, A., Hafez, M T., Roshdy, S., Setit, A., & Megahed, N. (2022, August 29). Primary thyroid chondrosarcoma: a case report of an extremely rare malignancy. Springer Nature, 34(1). https://doi.org/https://doi.org/10.1186/s43046-022-00138-z
- Düzcü, S E., Coşgun, Z., & Astarcı, H M. (2020, January 1). Laryngeal chondrosarcoma of the thyroid cartilage. Federation of Turkish Pathology Societies. https://doi.org/https://doi.org/10.5146/tjpath.2020.01509
- Kinsella, A R., Corbett, M., Hacking, S., & Lang, J. (2023, January 1). Chondrosarcoma of the thyroid cartilage: surgical management of a rare case. BMJ, 16(1), e251654-e251654. https://doi.org/https://doi.org/10.1136/bcr-2022-251654
- Nachawi, N., Lew, M., Konopka, K E., & Sandouk, Z. (2020, March 11). A challenging case of Mesenchymal Chondrosarcoma involving the thyroid and special considerations for diagnosis. BioMed Central, 6(1). https://doi.org/https://doi.org/10.1186/s40842-020-00094-4
- Sun, G H., Wang, Y J., Gao, L., Qu, N., Mu, X M., Shi, R., & Ji, Q. (2016, October 13). Primary chondrosarcoma of the thyroid cartilage: Surgery-based management of a rare case. Spandidos Publishing, 12(6), 4435-4438. https://doi.org/https://doi.org/10.3892/ol.2016.5257